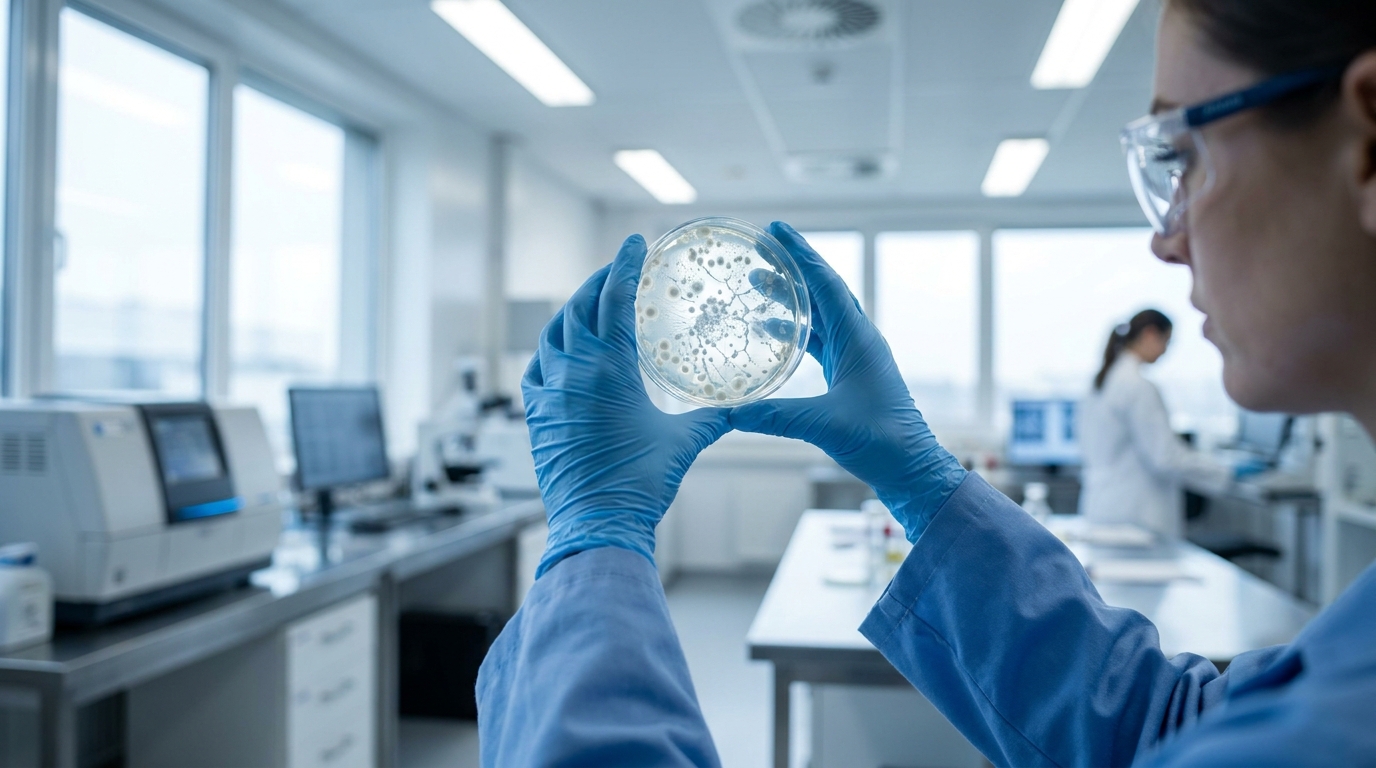

Des chercheurs conçoivent un neurone artificiel capable de communiquer avec un véritable cerveau
Auteur: Mathieu Gagnon
Le défi énergétique de l’intelligence artificielle face à la biologie

Les systèmes d’apprentissage automatique les plus avancés réalisent des tâches complexes, mais il existe une compétence spécifique pour laquelle ils ne peuvent rivaliser avec la matière grise humaine : l’efficacité brute du calcul. Le cerveau humain fonctionne de manière similaire à un ordinateur extrêmement puissant tout en ne consommant qu’environ 20 watts d’énergie. En comparaison, les centres de données dédiés à l’intelligence artificielle nécessitent des millions de watts pour fonctionner, tout en consommant d’importantes quantités d’eau. Cette demande énergétique se fait au détriment de l’environnement et se répercute directement sur les factures d’électricité.
Les scientifiques observent cet écart énergétique massif entre la biologie humaine et l’informatique artificielle depuis des décennies. Ils cherchent des solutions pour fusionner ces deux domaines. Dans une époque où tout semble être de l’intelligence artificielle, la nécessité de concevoir des systèmes plus efficaces devient primordiale pour conserver l’énergie et les autres ressources matérielles. C’est dans ce contexte de recherche d’optimisation que de nouvelles avancées ont été réalisées concernant les réseaux neuronaux de synthèse.
Une communication inédite entre composants artificiels et cellules vivantes
Une nouvelle étude publiée dans la revue Nature Nanotechnology explore une méthode inédite pour créer des neurones artificiels capables de parler de manière effective avec des cellules cérébrales vivantes. L’objectif de cette recherche est de fournir une plateforme flexible, similaire à celle des neurones biologiques, qui posséderait des avantages énergétiques par rapport aux dispositifs en silicium, connus pour leur puissance mais limités par leur rigidité matérielle.
Mark Hersam, auteur principal de l’étude et chercheur à l’Université Northwestern, a déclaré dans un communiqué de presse : « La façon dont vous rendez l’intelligence artificielle plus intelligente est en l’entraînant sur de plus en plus de données. Cet entraînement intensif en données conduit à un problème massif de consommation d’énergie ». Il apporte une précision sur la viabilité du modèle biologique en ajoutant : « Parce que le cerveau est cinq ordres de grandeur plus économe en énergie qu’un ordinateur numérique, il est logique de se tourner vers le cerveau pour trouver l’inspiration pour l’informatique de la prochaine génération. »
L’architecture du cerveau humain comme modèle d’adaptabilité

La conception d’un neurone artificiel constitue le point de départ de ce projet scientifique. Le cerveau humain moyen contient environ 86 milliards de neurones. Notre structure cérébrale abrite une quantité de neurones dans le cortex cérébral supérieure à celle de la plupart des animaux. Cette région spécifique du cerveau est responsable de processus complexes tels que la conscience, la pensée, la mémoire, l’émotion et le langage.
Les dispositifs en silicium actuels intègrent des milliards de transistors. S’ils délivrent une puissance de calcul importante, ils n’offrent pas la même flexibilité que les neurones humains. Le tissu biologique est capable de remodeler son architecture ou même d’abandonner certaines connexions au fil du temps. Cette plasticité naturelle est le mécanisme qui permet aux êtres humains d’apprendre de nouvelles informations et de s’adapter à leur environnement en utilisant très peu d’énergie au quotidien.
Le procédé d’impression par jet d’aérosol et la chimie des matériaux

Pour fabriquer ces neurones artificiels, Mark Hersam et son équipe se sont appuyés sur l’impression par jet d’aérosol. Cette technique est couramment employée dans l’industrie pour produire des composants électroniques tels que des résistances et des condensateurs. Les chercheurs ont utilisé des encres électroniques agissant à la fois comme conducteur électrique et comme semi-conducteur. La formule de ces encres intègre du graphène ainsi que des flocons de disulfure de molybdène, ce dernier jouant le rôle de semi-conducteur pour le neurone.
Par le passé, l’utilisation de polymères a posé certaines difficultés, car ces matériaux ont tendance à interférer avec le courant électrique. Pour résoudre ce problème, l’équipe a développé une méthode visant à rendre le substrat plus semblable à un cerveau. « Au lieu de retirer complètement le polymère, nous le décomposons partiellement », a expliqué Mark Hersam. « Ensuite, lorsque nous faisons passer du courant à travers le dispositif, nous entraînons une décomposition plus poussée du polymère. Cette décomposition se produit de manière spatialement inhomogène, conduisant à la formation d’un filament conducteur, de telle sorte que tout le courant est resserré dans une région étroite de l’espace. »
Cette voie étroite permet au polymère encré de se comporter davantage comme un véritable neurone. Le dispositif peut ainsi produire des impulsions uniques, des décharges continues ou des modèles d’éclatement, au lieu de se limiter à une simple impulsion unique et isolée.
Des tests validés sur des tissus biologiques et les prochaines étapes

L’expérimentation décisive s’est déroulée lorsque l’équipe de recherche a interfacé ces neurones artificiels avec un fragment de cervelet de souris. Les résultats ont confirmé que les tensions électriques artificielles correspondaient aux tensions biologiques. Le dispositif a même déclenché une activité au sein du tissu cérébral de l’animal. Cette interaction directe marque un jalon dans la communication entre la matière électronique et la biologie cellulaire.
Concernant les matériaux utilisés jusqu’à présent dans le milieu de la recherche, Mark Hersam a précisé les défis rencontrés par la profession : « D’autres laboratoires ont essayé de fabriquer des neurones artificiels avec des matériaux organiques, et ils émettaient des impulsions trop lentement. Ou ils ont utilisé des oxydes métalliques, qui sont trop rapides », a-t-il détaillé. « Nous avons démontré des signaux qui ont non seulement la bonne échelle de temps mais aussi la bonne forme d’impulsion pour interagir directement avec des neurones vivants. »
Des travaux supplémentaires restent nécessaires pour perfectionner ces neurones artificiels. Les chercheurs devront franchir des étapes additionnelles pour créer des synapses artificielles capables de relier l’ensemble du système. Cette étude démontre toutefois que la création des blocs de construction d’un futur ordinateur à intelligence artificielle, calqué sur le cerveau, est du domaine du possible. La science nécessite désormais le mortier cérébral et les plans cognitifs détaillés pour transformer ce rêve vieux de plusieurs décennies en une réalité pensante.
Selon la source : popularmechanics.com